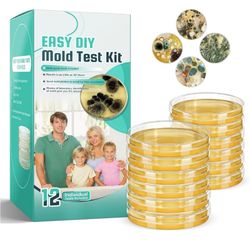
Mold Test Kit for Home Detection: 12 Professional DIY Testing Kits for Home Surfaces & Air Quality Detector & HVAC Monitor

Business equipment
Sub categories
Selected filters
Current listings
 Toco asador / plancha / parrilla$500Los Angeles, CA
Toco asador / plancha / parrilla$500Los Angeles, CA Pneumatic Framer $50Huntington Park, CA
Pneumatic Framer $50Huntington Park, CA Brand New Ergonomic Foot Rest Footrest Wedge $10East Los Angeles, CA
Brand New Ergonomic Foot Rest Footrest Wedge $10East Los Angeles, CA 10X20 Metal Carport With Galvanized Roof$880Rosemead, CA
10X20 Metal Carport With Galvanized Roof$880Rosemead, CA $875$875Los Angeles, CA
$875$875Los Angeles, CA Brand New Desk Riser Desktop Riser Standing Desk Monitor Stand$25East Los Angeles, CA
Brand New Desk Riser Desktop Riser Standing Desk Monitor Stand$25East Los Angeles, CA $875$875Los Angeles, CA
$875$875Los Angeles, CA New 30"x22"x 9”Granite Composite Kitchen Sink Drop In Workstation Topmount Large Deep Single Bowl$155Whittier, CA
New 30"x22"x 9”Granite Composite Kitchen Sink Drop In Workstation Topmount Large Deep Single Bowl$155Whittier, CA Brand New Book Shelf Printer Stand With Storage Pouch $25East Los Angeles, CA
Brand New Book Shelf Printer Stand With Storage Pouch $25East Los Angeles, CA Baghera Gas Station for kids$120South Gate, CA
Baghera Gas Station for kids$120South Gate, CA New 30 Inch White Granite Composite Sink Workstation, 30 X 18 White Undermount Kitchen Sink$155Whittier, CA
New 30 Inch White Granite Composite Sink Workstation, 30 X 18 White Undermount Kitchen Sink$155Whittier, CA Buying all Ascended and Primsatic Products$1Moorpark, CA
Buying all Ascended and Primsatic Products$1Moorpark, CA New TORVA RV Kitchen Sink, 13 x 15 x 9 Inch Undermount Bar Sink Premium Stainless Steel Single Bowl$100Whittier, CA
New TORVA RV Kitchen Sink, 13 x 15 x 9 Inch Undermount Bar Sink Premium Stainless Steel Single Bowl$100Whittier, CA New TORVA RV Kitchen Sink, 16 x 21 x 9 Inch Undermount Bar Sink 16 Gauge Stainless Steel Single Bowl$120Whittier, CA
New TORVA RV Kitchen Sink, 16 x 21 x 9 Inch Undermount Bar Sink 16 Gauge Stainless Steel Single Bowl$120Whittier, CA New MENSARJOR Bar Sink, 14 x 14 inch Undermount Kitchen Sink, 16 Gauge Stainless Steel Sink$60Whittier, CA
New MENSARJOR Bar Sink, 14 x 14 inch Undermount Kitchen Sink, 16 Gauge Stainless Steel Sink$60Whittier, CA Kicking box$100Huntington Park, CA
Kicking box$100Huntington Park, CA Table Riser$90Bellflower, CA
Table Riser$90Bellflower, CA Used $150 everything in great condition$150Long Beach, CA
Used $150 everything in great condition$150Long Beach, CA Superior Pump 1/2 HP Shallow Well Jet Pump$150Bellflower, CA
Superior Pump 1/2 HP Shallow Well Jet Pump$150Bellflower, CA Brasscraft Gas Hose$10Long Beach, CA
Brasscraft Gas Hose$10Long Beach, CA Tall Display Cabinets $2,400Los Angeles, CA
Tall Display Cabinets $2,400Los Angeles, CA 20 Pounder Noz Tank $160Los Angeles, CA
20 Pounder Noz Tank $160Los Angeles, CA Wine Racks $50Bell Gardens, CA
Wine Racks $50Bell Gardens, CA Dolly $25Bell Gardens, CA
Dolly $25Bell Gardens, CA Display Shelf with Dimmable LED Floor Lamp$35Temple City, CA
Display Shelf with Dimmable LED Floor Lamp$35Temple City, CA NEW TRAILER TIRE 6 LUGS,225/75R15
SALE TIRE AND WHEEL EACH FOR SALE TOGHETER,ESPECIAL FOR TRAILERS ONLY FOR ANY QUESTION TEXT ME PLEASE HABLO ESPAÑOL$169Los Angeles, CA
NEW TRAILER TIRE 6 LUGS,225/75R15
SALE TIRE AND WHEEL EACH FOR SALE TOGHETER,ESPECIAL FOR TRAILERS ONLY FOR ANY QUESTION TEXT ME PLEASE HABLO ESPAÑOL$169Los Angeles, CA Mold Test Kit for Home Detection: 12 Professional DIY Testing Kits for Home Surfaces & Air Quality Detector & HVAC Monitor$18Los Angeles, CA
Mold Test Kit for Home Detection: 12 Professional DIY Testing Kits for Home Surfaces & Air Quality Detector & HVAC Monitor$18Los Angeles, CA New Owening R15 Faced KraftR-15 Insulation 3.5” x15” x93”$30El Monte, CA
New Owening R15 Faced KraftR-15 Insulation 3.5” x15” x93”$30El Monte, CA Remove all Junk $100Los Angeles, CA
Remove all Junk $100Los Angeles, CA Scaffolding, Platform, Plataforma, Andarme $120Downey, CA
Scaffolding, Platform, Plataforma, Andarme $120Downey, CA Rising Desk Standing Desk Riser New$110El Monte, CA
Rising Desk Standing Desk Riser New$110El Monte, CA Brand New 24x110 Inch Acoustic Slat Wall Panels $79El Monte, CA
Brand New 24x110 Inch Acoustic Slat Wall Panels $79El Monte, CA Kneeling Chair $85Bell Gardens, CA
Kneeling Chair $85Bell Gardens, CA Rising Desk Standing Desk Riser New$165El Monte, CA
Rising Desk Standing Desk Riser New$165El Monte, CA Pressure Washer$900Downey, CA
Pressure Washer$900Downey, CA Pressure Washer$350Downey, CA
Pressure Washer$350Downey, CA Standing desk$85Los Angeles, CA
Standing desk$85Los Angeles, CA Bambu Lab 2pro$300Los Angeles, CA
Bambu Lab 2pro$300Los Angeles, CA Car 🚗 Wash 🧼 &detail 🧽 Mobil$80Los Angeles, CA
Car 🚗 Wash 🧼 &detail 🧽 Mobil$80Los Angeles, CA Transportation Chair$100Monrovia, CA
Transportation Chair$100Monrovia, CA 1000W Solar Street Lights Replacement, 60000LM Solar Lights Outdoor Waterproof, Dusk to Dawn Commercial Parking Lot Lights, Solar Flood Lights Outdoor$30El Monte, CA
1000W Solar Street Lights Replacement, 60000LM Solar Lights Outdoor Waterproof, Dusk to Dawn Commercial Parking Lot Lights, Solar Flood Lights Outdoor$30El Monte, CA Dri-Eaz Water Restoration Equipment Professional Dehumidifier $1,350Huntington Park, CA
Dri-Eaz Water Restoration Equipment Professional Dehumidifier $1,350Huntington Park, CA Asphalt Milling Bits$100Whittier, CA
Asphalt Milling Bits$100Whittier, CA 100$100Norwalk, CA
100$100Norwalk, CA Toshiba air conditioner used in good condition$100South Gate, CA
Toshiba air conditioner used in good condition$100South Gate, CA New 33 Inch Undermount Kitchen Sink Double Bowl 50/50 Stainless Steel 18 Gauge Under Counter Kitchen$130Whittier, CA
New 33 Inch Undermount Kitchen Sink Double Bowl 50/50 Stainless Steel 18 Gauge Under Counter Kitchen$130Whittier, CA Shark power detect$225Hawaiian Gardens, CA
Shark power detect$225Hawaiian Gardens, CA New 15x15 Inch Drop In Bar Sink Topmount Single Bowl Handmade 16 Guage Stainless Steel Small Kitchen$50Whittier, CA
New 15x15 Inch Drop In Bar Sink Topmount Single Bowl Handmade 16 Guage Stainless Steel Small Kitchen$50Whittier, CA Security Gate $30Bell Gardens, CA
Security Gate $30Bell Gardens, CA Patient Lift for Home, Power Shower Chair with Wheels and 360° Split Seat, Portable Transport Wheelchair with Soft Back and Urinal, 5 in 1 Transfer Ch$800El Monte, CA
Patient Lift for Home, Power Shower Chair with Wheels and 360° Split Seat, Portable Transport Wheelchair with Soft Back and Urinal, 5 in 1 Transfer Ch$800El Monte, CA